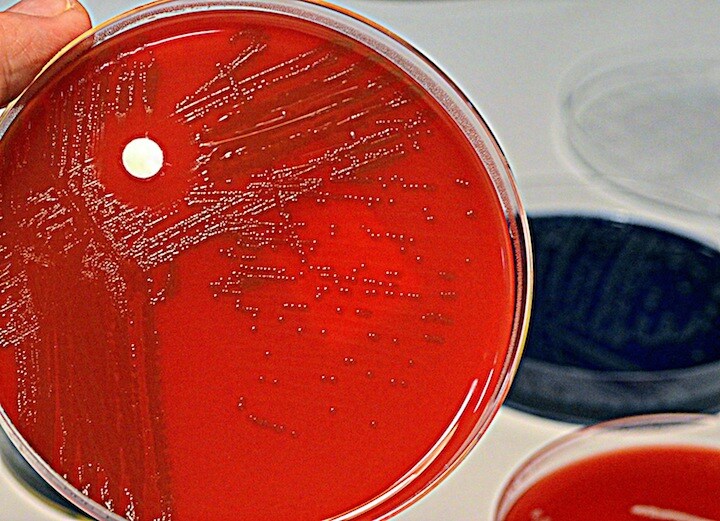
どの抗生物質も効かない…… REUTERS/Fabrizio Bensch

表皮ブドウ球菌の変異株3種
「スーパーバグ」(超細菌)といえば抗生物質が効かない細菌だが、複数の抗生物質が効かないものが人知れず世界中の病院にじわじわと広がっている――オーストラリアの科学者がこのほど、そんな警告を発した。
治療がほぼ不可能な「スーパーバグ」を発見したのは、オーストラリアのメルボルンにあるドハティ感染免疫研究所の研究者たち。英科学誌ネイチャー・マイクロバイオロジーに発表した。ドハティ研究所は、メルボルン大学と王立メルボルン病院の共同事業だ。
ドハティ研究所の発表文によると研究チームは、世界10カ国、78の研究所から受け取った表皮ブドウ球菌の数百もの分離株を調べた。そこで、ほとんどの抗生物質に耐性を持つ変異株3種類が見つかったという。研究チームは、これらが世界中に広がっていると考えており、なかでも、ヨーロッパのサンプルから見つかったものは、現在使用できる抗生物質すべてに耐性を持っているため警戒が必要だと指摘している。
DNAに異変を起こして耐性を作ったスーパーバグ
研究チームによると、表皮ブドウ球菌のこれら3種は、メチシリン耐性黄色ブドウ球菌の近縁種。自らのDNA(遺伝子)にわずかに異変を起こして、2つの抗生物質に対する耐性を持つようになった。
オーストラリアの薬局に関するニュースを発信するサイト「ファーマシー・ニュース」はこの2つの抗生物質をリファンピシンとバンコマイシンとしている。これらの抗生物質は互いに関連性がないため、細菌がどちらか1つに耐性を持ったとしても、もう1つが効くという前提で治療が行われている。そのため現在のガイドラインでは、表皮ブドウ球菌の感染はこの2つの抗生物質を使って予防するよう定めているという。しかしこのどちらも効かないとなると、ガイドラインを見直す必要がある、と研究チームは述べている。
カテーテルなどの人工物や集中治療室が原因か
これらの表皮ブドウ球菌は通常、あらゆる人の肌で見つかるものだ。しかし体内に侵入すると感染症を引き起こすことがある。
研究チームによると、表皮ブドウ球菌が耐性を持ってしまい感染症が蔓延する原因には2つの可能性がある。1つはカテーテルや人工関節などの人工物は通常、感染予防のために抗生物質を用いており、これが原因で表皮ブドウ球菌が耐性を持ってしまうというものだ。